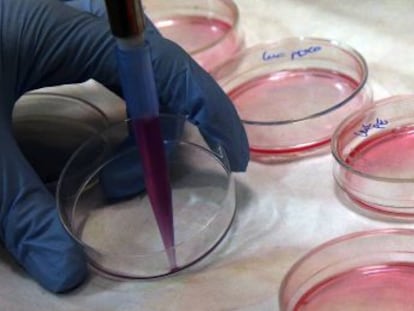

El Hospital de Manises traslada a casa al paciente de 350 kilos en un camión y contra su criterio
La familia denuncia que el desplazamiento se ha realizado en un vehículo "para transportar cosas"

El Hospital de Manises (Valencia) ha trasladado finalmente este martes a su pueblo a Teófilo Rodríguez, el hombre de 350 kilos a quien la semana pasada quiso dar el alta con el argumento de que carecía de medios para tratarlo debido a sus características físicas, según denunció la familia. La salida del hospital se ha hecho contra la opinión del paciente, de 34 años, y sus familiares, que consideran que debía permanecer en el hospital debido a su estado de salud, que incluye dificultad respiratoria, inmovilidad y llagas en la espalda. También les preocupa el largo tiempo que requeriría un nuevo desplazamiento al hospital en caso de que su situación se agrave y necesite atención urgente. En poco más de un mes, Rodríguez ha estado ingresado tres veces.
Al otro lado del teléfono, la hermana del hombre, Dévora Rodríguez, sonaba este martes agitada: "Han trasladado a mi hermano en un camión para transportar cosas, un camión de mudanzas. No es un vehículo adaptado para él". Este periódico ha intentado sin éxito obtener las versiones del hospital y de la Consejería de Sanidad.
La hermana, de 24 años, contaba desde Turís, un pueblo situado a 35 kilómetros de Valencia, que al no encontrar una ambulancia bariátrica adecuada, el hospital había decidido subir la cama en la que estaba ingresado en un camión de transporte de mercancías. "Hemos estado tres horas en la puerta de mi casa, pero no sabían cómo bajarlo ni qué hacer con él. Han dicho de llevarlo al polideportivo, y al final lo han traído al centro de salud de Turís. Ahora está en una sala de espera de pediatría".
En un vídeo enviado por la familia, el paciente critica el viaje desde el interior del vehículo: “Me han traído en un camión sin aire acondicionado ni nada. Tengo un calor que me muero. No veo justo no poder ir en una camilla como cualquier ciudadano”.
Rodríguez ha sido transportado en otras ocasiones en una camilla que soporta su peso. La última vez que lo llevaron al hospital, se utilizó, en cambio, una camilla que solo soportaba 318 kilos y que se rompió cuando una docena de bomberos y policías lo subieron a ella.
La semana pasada, 48 horas después de ingresar por última vez, el Hospital de Manises, que es de titularidad pública y gestión privada —el llamado modelo Alzira—, comunicó a Rodríguez que le iba a dar el alta. Cuando sus familiares vieron que iban a llevárselo en una camilla como la que se rompió, se negaron. Desde entonces, el paciente ha permanecido ingresado mientras el hospital buscaba la forma de llevarlo a casa.
Agravamiento
La hermana de Rodríguez afirma que su hermano es obeso desde que a los nueve años sufrió un problema de tiroides. Pero hasta este verano era independiente, y desde hace un año vivía con su novia en un chalé de Turís. En julio las piernas se le hincharon, dejó de poder caminar y desde entonces su estado no ha parado de empeorar. En el penúltimo ingreso, un médico le dijo a Dévora Rodríguez que se hicieran a la idea de que su hermano iba a morirse. La obesidad mórbida puede provocar fallos multiorgánicos, señalan fuentes sanitarias.
El padre de Rodríguez sufre alzheimer y del cuidado de ambos hombres en el hogar familiar se ocupan su novia, su madre y su hermana. Las pensiones de ambos varones, que son los únicos ingresos de la casa, suman 2.000 euros. Cuando pidieron ayuda a los servicios sociales municipales para asear a su hermano, al que tienen problemas para mover, Dévora Rodríguez dice que les contestaron que solo podían mandarles a una "chica para limpiar la casa".
Tu suscripción se está usando en otro dispositivo
¿Quieres añadir otro usuario a tu suscripción?
Si continúas leyendo en este dispositivo, no se podrá leer en el otro.
FlechaTu suscripción se está usando en otro dispositivo y solo puedes acceder a EL PAÍS desde un dispositivo a la vez.
Si quieres compartir tu cuenta, cambia tu suscripción a la modalidad Premium, así podrás añadir otro usuario. Cada uno accederá con su propia cuenta de email, lo que os permitirá personalizar vuestra experiencia en EL PAÍS.
¿Tienes una suscripción de empresa? Accede aquí para contratar más cuentas.
En el caso de no saber quién está usando tu cuenta, te recomendamos cambiar tu contraseña aquí.
Si decides continuar compartiendo tu cuenta, este mensaje se mostrará en tu dispositivo y en el de la otra persona que está usando tu cuenta de forma indefinida, afectando a tu experiencia de lectura. Puedes consultar aquí los términos y condiciones de la suscripción digital.
Sobre la firma

Más información
Archivado En
Últimas noticias
El temporal sigue activo en Cataluña y pone al límite el caudal de los ríos en Girona
Desaparecidos cuatro miembros de una familia española en un naufragio en Indonesia
Los grandes derrotados del Gordo de Navidad de Villamanín, 15 jóvenes de entre 18 y 25 años: “Hoy hemos perdido amigos”
Elon Musk, Jeff Bezos y Amancio Ortega… así cerraron el año los hombres más ricos del planeta
Lo más visto
- Acuerdo en Villamanín por el Gordo sin repartir: la comisión de fiestas cede más de dos millones por la paz del pueblo
- Junqueras avisa de que la recaudación del IRPF es “imprescindible” para negociar los presupuestos de Sánchez e Illa
- Maisa Hens, cantante: “Gracias al anuncio de El Almendro no tuve que volver a hacer un ‘casting”
- Timothy Morton, activista: “Estados Unidos es un gigantesco campo de concentración”
- El PP de Ayuso veta la comisión de investigación que pidió Más Madrid para el hospital de Torrejón